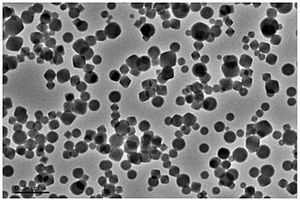

全部

 814
814
 0
0
本发明涉及一种用于锂离子电池正极的补锂添加剂、包含该补锂添加剂的锂离子电池正极材料和包含该正极材料的锂离子电池。所述补锂添加剂为Li3N/H3BO3/M纳米复合材料,其中M为选自Ni、Co、Fe、Mn、Cr、Cu和Zn中的一种或几种过渡金属,所述Li3N的含量占所述补锂添加剂总质量的50%‑99.8%,所述H3BO3的含量占所述补锂添加剂总质量的0.1%‑40%,以及所述过渡金属M的含量占所述补锂添加剂总质量的0.1%‑40%。所述补锂添加剂能够在首次充电时提供锂源,补偿形成SEI膜所消耗的锂,提升首次库伦效率和循环性能,尤其适用于硅碳、硅氧等首次库伦效率低的负极材料。

本发明公开了一种利用稻壳生物炭改性CuCo2O4的制备方法,包括如下步骤:步骤1、取一定量Co(NO3)2·6H2O、Cu(NO3)2·3H2O、生物炭RHBC混合均匀后放入马弗炉中煅烧得到样品;步骤2、将所述样品先用超纯水洗涤,再用乙醇洗涤,之后真空干燥得到RHBC‑CuCo2O4。本发明还提供上述的制备方法得到的RHBC‑CuCo2O4在活化过硫酸盐去除水中污染物中的应用。该复合材料环境友好,金属浸出率低,在基于过氧硫酸盐的高级氧化过程中,可高效去除水中有机污染物。

 750
750
 0
0
本发明的一种改性锂离子电池隔膜的制备方法属于锂离子电池隔膜修饰的技术领域,步骤包括配制Zn(AC)2·2H2O和CTAB的乙醇溶液、混合形成淡黄色沉淀、加入纳米金刚石加热得到纳米金刚石/氧化锌复合材料ZnO/NDs、制备NDs胶体溶液或ZnO/NDs胶体溶液、涂覆在聚丙烯隔膜上得到改性锂离子电池隔膜材料等。本发明制备的新型隔膜修饰材料具有良好的电化学性能,用其制作的锂离子电池,具有良好的循环稳定性和递增的容量。

 1058
1058
 0
0
本发明公开了不锈钢S11348复合钢板的爆炸焊接方法,包括基材、复材,复材和基材经过爆炸焊接后结合到一起形成一种新的复合材料,结合界面成均匀细波纹状,它具有强度高、耐腐蚀性好的优点,适用范围广。

本发明公开了一种利用银杏叶提取物构筑氧化锌/凹凸棒石纳米复合抗菌材料的方法,是在银杏叶水提物中加入凹凸棒石,搅拌均匀后滴加锌盐溶液,采用氢氧化钠调节pH值为7~11,得到前驱体混合液;将上述前驱体混合液在搅拌和55~95℃恒温油浴条件下反应30~180min,所得产物离心洗涤,干燥,得到氧化锌/凹凸棒石复合抗菌材料。本发明以银杏叶提取物为还原剂和稳定剂,一步法构筑凹凸棒石‑氧化锌复合材料,对革兰氏阳性菌和革兰氏阴性菌均表现出优异的抗菌性能。该制备方法取材方便、工艺操作简单、成本低廉、绿色环保,易于规模生产。

本发明公开了高透光率高韧性的PETG‑PC合金及制备方法和应用,涉及高分子复合材料技术领域。高透光率高韧性的PETG‑PC合金的原料包括:PETG树脂40‑85份、PC树脂20‑50份、成核剂0.05‑0.3份、抗氧剂0.1‑0.4份、增塑剂1‑3份、润滑剂0.3‑2份、酯交换抑制剂0.05‑0.3份和扩链剂0.05‑0.2份。利用PETG树脂、PC树脂为主要原料,配合成核剂、抗氧剂、增塑剂、润滑剂、酯交换抑制剂和扩链剂,在改善PETG树脂脱模性能的前提下,还能够获得具有良好透光率、高耐化性、高韧性和低吸水性的复合合金材料,具有广阔的应用前景。

 898
898
 0
0
本发明公开了一种复合聚酰亚胺膜及其制备方法,将球磨磷酸铝、环氧有机硅树脂、双酚A环氧树脂、脂环族环氧树脂、聚酰胺、二月桂酸二丁基锡混合,得到粘结剂;然后将粘结剂涂在聚酰亚胺薄膜上,再覆盖玻璃布,热定型后热压,得到复合聚酰亚胺膜。针对聚酰亚胺薄膜/玻璃布复合产品应用广泛的现状,为了解决市售胶黏剂对复合材料性能提升不佳的问题,本发明采用自配的胶黏剂,得到的复合聚酰亚胺膜拉伸强度有所提升,且绝缘性能比如耐电压符合应用要求。

 857
857
 0
0
本发明公开了一种免喷涂聚丙烯材料及其制备方法。免喷涂聚丙烯材料采用低取向色粉,所述低取向色粉是通过以下步骤获得的:在超声的条件下,向硅烷偶联剂溶液中加入纳米炭,超声10‑15min后,加入色粉,继续超声,并搅拌30‑40min后得到低取向色粉。本发明的聚丙烯材料采用低取向色粉,改性色粉采用纳米炭为载体,色粉负载在纳米炭的表面,形成规律的色粉包覆纳米炭,在免喷涂复合材料中对光线的反射较较均匀、一致,主要发生点反射,因此材料表面光泽度较高。

 1078
1078
 0
0
本发明涉及一种ZnO@SiO2纳米胶囊的制备方法,属于纳米材料技术领域,包括以下步骤:步骤1、有机酸锌盐的制备;步骤2、ZnO@SiO2纳米复合材料的制备。本发明的一种ZnO@SiO2纳米胶囊的制备方法,利用长链羧酸盐作为结构导向剂、正硅酸乙酯和氨基硅烷作为硅源,有机酸锌盐作为前驱体,在水醇体系中先后进行一系列连续自发反应,得到有机—无机杂化纳米材料,最后通过煅烧得到ZnO@SiO2纳米胶囊;利用配体交换反应将有机酸锌盐和作为结构导向剂的长链羧酸钠相连,保证金属离子可大量引入二氧化硅基体中;该制备方法反应条件温和,无需另加酸性或碱性催化剂,可以得到分散性较好的ZnO纳米粒子。

 618
618
 0
0
本发明属于复合材料制备技术领域,具体涉及一种自组装MXene/壳聚糖复合膜及其制备方法和应用,所述复合膜由层状MXene纳米片层层叠加而成,所述层状MXene纳米片表面自组装包覆有壳聚糖。利用壳聚糖在MXene纳米片表面的自组装,削弱纳米片间的堆叠,实现复合膜的高规整度,并且直接将复合膜用做锂离子电池的集流体,利用复合膜的高导电性、表面大量亲金属基团(羟基、胺基等),来诱导金属平面沉积,抑制电池运行过程中的枝晶生长,从而保证金属负极二次电池的安全、稳定、高效运行。本发明中采用的壳聚糖作为天然绿色多糖,安全环保,而且复合膜的制备方法简单可控,适合扩大化生产。

本发明属于锂电池材料技术领域,提供了一种三维多孔结构的纳米碳/钛酸锂复合包覆正极材料的制备方法。该方法将黄原胶和含钛化合物混合制备黄原胶复合二氧化钛混合液,然后加入正极材料,剧烈搅拌反应完全后,经冷冻、真空干燥、与锂盐混合后预烧、退火,得到三维多孔结构的纳米碳/钛酸锂复合包覆正极材料。与传统方法相比较,本发明制备的三维多孔结构的纳米碳/钛酸锂复合包覆正极材料,通过形成碳纳米纤维/钛酸锂纳米颗粒复合材料均匀包覆在正极材料的表面,具有良好的循环稳定性、倍率性能、安全性能、有效抑制电化学阻抗的优点。

 855
855
 0
0
本发明属于复合材料领域,尤其涉及一种钼尾矿陶粒及其制备方法。本发明提供的钼尾矿陶粒以重量份数计,其原料组分包括:钼尾矿50~70份;陶瓷抛光废粉5~10份;粉煤灰10~25份;石灰石粉5~20份;水泥5~15份;石膏1~5份;碱激发剂2~8份;水10~20份。本发明提供的钼尾矿陶粒以钼尾矿和陶瓷抛光废粉作为生产原料,实现了钼尾矿和陶瓷抛光废粉的资源化利用;同时该陶粒有良好的抗渗性及抗压性,并且具有良好的后期强度。本发明提供的钼尾矿陶粒制作工艺简便,低能耗,可广泛应用于制备轻质高强混凝土、透水混凝土等建筑材料,具有显著的经济效益、环境效益和社会效益。

本发明公开了一种聚吡咯/二氧化钛/石墨相氮化碳三元复合光催化材料及其制备方法,属于复合材料技术领域。包括如下步骤:将氮化碳粉末加入浓硫酸中,磁力搅拌,制备剥离的石墨相氮化碳纳米片;离心洗涤后收集,干燥;将得到的石墨相氮化碳纳米片配置成悬浮水溶液;在冰水浴的环境中,将二氧化钛先分散于水中,加入吡咯单体,加入氧化剂;后加入石墨相氮化碳纳米片悬浮水溶液,利用原位聚合法制备聚吡咯/二氧化钛/石墨相氮化碳三元复合光催化材料;洗涤后过滤收集,真空干燥。本发明有益效果为:操作简单,成本低廉。该项技术的发明,即聚吡咯/二氧化钛/石墨相氮化碳三元复合光催化材料,作为光催化材料在污水处理等方面具有广阔的应用前景。

 642
642
 0
0
本发明涉及一种硅酸银和二氧化钛四面纳米棒复合催化剂,属于纳米复合材料和光催化技术领域。一种硅酸银和二氧化钛四面纳米棒复合催化剂,所述催化剂以二氧化钛纳米管为载体,采用一步水热法合成了硅酸银和二氧化钛四面纳米棒异质结复合催化剂;所述硅酸银纳米粒子沉积在二氧化钛的四个(100)暴露晶面上,二氧化钛的四个(100)暴露晶面分别与硅酸银的(‑116)晶面紧密结合构筑了异质界面。

 623
623
 0
0
本发明涉及一种烟气脱硝催化剂,其特征在于,采用如下方法制备:(1)将锰盐、镍盐和尿素、氟化铵溶于体积比为1:(1‑2)的乙二醇和丙三醇混合溶剂中,将混合液转入高压反应釜中,溶剂热反应后以去离子水和乙醇交替洗涤3次;将产物在空气条件下进行热处理,热处理温度为300‑400摄氏度,热处理时间为1‑3h,得到粒径尺寸为500‑1000纳米的花状NiMnO3;(2)将NiMnO3溶于去离子水中,随后加入钛酸四丁酯和聚乙烯吡咯烷酮、Sr盐,90‑150摄氏度下边搅拌边反应10‑20h,随后以去离子水和乙醇洗涤三次,将产物在空气条件下进行热处理,热处理温度为350‑400摄氏度,热处理时间为1‑3h,得到NiMnO3‑Sr掺TiO2复合材料。

 964
964
 0
0
本发明涉及铜基纳米复合材料技术领域,具体涉及一种铜合金碳纳米管复合粉体及其制备方法和应用。所述碳纳米管分布于复合粉体表面,所述复合粉体由铜合金粉化学气相沉积制备得到,所述铜合金粉中至少包含铝、铬、铁、锰、铼元素中的至少一种;所述铝、铬、铁、锰、铼元素中的一种或多种成分的总含量按重量百分比计为0.05%~1%。提供的一种新型铜合金碳纳米管复合粉体的制备方法,不需要将Co、Ni催化剂分散到铜粉上也可以实现在铜粉上直接合成碳纳米管,大大简化了流程,降低了成本,且利于工业化批量生产。

本发明公开了一种用于钾硫电池的鳞片状氮掺杂碳复合钼掺杂二氧化钛‑硫电极的制备方法及其应用,通过简单高效的热分解方法制备独特的鳞片状碳,通过简单易得的溶胶凝胶法和一步水热法制备Mo@TiO2,通过调控N@C和Mo@TiO2的质量比,构建独特的鳞片状N@C/Mo@TiO2复合材料双重吸附多硫化物,受协同效应的影响,结合鳞片状氮掺杂碳和Mo@TiO2高效物理、化学吸附多硫化物,抑制穿梭效应的产生,并且工艺简单新颖,成本低,可快速制备,进一步提高电池的电化学性能以及为钾硫电池和其它储能设备的开发提供了有前景的策略。

 752
752
 0
0
本发明提供了一种金属有机框架纳米酶生物探针和ELISA试剂盒,涉及生物免疫传感技术领域。本发明采用的金属有机框架纳米复合材料ZIF‑67/Cu0.76Co2.24O4具有良好的吸附性,能溶于水,可以结合抗体、适配体、多肽等具有识别作用的生物分子等特点,通过与特异性识别乳腺癌细胞的含巯基生物材料形成的生物探针具有良好的过氧化物酶和漆酶催化活性以及非生理条件下的结构稳定,能够催化显色底物快速显色,从而实现对乳腺癌细胞的快速可视化检测。本发明提供的特异性检测乳腺癌细胞的ELISA试剂盒对乳腺癌细胞的检测精确度高、灵敏度高、检测范围宽、成本低,具有重要的科学意义和临床应用价值。
784
784
 0
0
一种能够在可见光下降解新烟碱类农药的MOFS复合催化剂,包括核心的NH2‑UiO‑66(Zr)颗粒,以及附着在所述NH2‑UiO‑66(Zr)颗粒Pd微粒或者Ag微粒,其中,NH2‑UiO‑66(Zr)颗粒粒径在100‑200nm之间,Pd微粒或者Ag微粒的粒径约为5nm。本发明通过制备MOFs复合材料,利用MOFs与贵金属纳米粒子间产生的协同增效作用解决已有技术降解效率低的技术问题,拓展了材料的可见光响应范围,提高了光催化效率。

 981
981
 0
0
本发明公开了一种丁基缩水甘油醚甲基丙烯酸酯的制备方法,先将丁基缩水甘油醚、甲基丙烯酸、催化剂、阻聚剂放入四口烧瓶中,加热、搅拌,使物料混合均匀,升温至105~115℃,维持反应5~8h定时测量酸值,直至酸值小于5mgKOH/g时结束反应,冷却至室温后即制得丁基缩水甘油醚甲基丙烯酸酯。制备制得的低气味、低挥发的丁基缩水甘油醚甲基丙烯酸酯,具有成本低、粘度低、活性高、毒性低、沸点高、闪点高、固化收缩率低、柔韧性好等优点,可广泛应用于环保型绝缘漆、光固化涂料、光固化油墨、树脂复合材料等领域,可以较好地替代目前广泛使用而闪点低、挥发性大、毒性高、脆性大的苯乙烯。

 695
695
 0
0
本发明涉及聚合物复合材料技术领域,公开了一种改性环氧树脂及其使用方法,包括A组分和B组分;所述A组分的原料按重量份包括50~70份环氧树脂和15~25份改性二氧化硅填料;所述改性二氧化硅填料为使用硅烷偶联剂进行表面改性的二氧化硅纳米颗粒;所述B组分的原料按重量份包括8~20份胺类固化剂和1~3份固化催化剂;所述固化催化剂包括多孔PDMS纳米纤维载体和负载在所述多孔PDMS纳米纤维载体上的三乙基膦、三乙醇胺和改性石墨烯。本发明中胺类固化剂和固化催化剂配合使用,能够提高固化速率;固化催化剂本身还能够作为阻燃补强填料,提高耐热性能;改善环氧树脂与无机相间的两相界面,提高机械性能和化学性能。

 757
757
 0
0
本发明公开了一种复材壁板微小阵列孔通孔率检测系统,属于航空复合材料制造技术领域,包括检测计算机、数据采集处理单元和与检测计算机电连接的运动单元,其特征在于:所述运动单元包括示教器、运动机构、用于控制运动机构的控制器和用于对运动机构进行精度补偿的精度补偿模块,所述数据采集处理单元包括用于采集制孔表面形貌的二维点云轮廓数据的数据采集传感器和用于对数据进行分析诊断并过滤噪声点云的数据处理模块,所述数据采集传感器与数据处理模块电连接,数据处理模块与检测计算机电连接。本发明能够实现微小阵列孔通孔率的自动化检测,不仅能够进行快速检测,而且能够有效提高检测精度。

 846
846
 0
0
本发明公开了一种磁性活性炭的制备方法及其在烟气脱汞中的应用,涉及复合材料制备技术领域,包括如下步骤:(1)按比例称取活性炭、铁的可溶性盐、镍的可溶性盐和锌的可溶性盐溶于无水乙醇或去离子水中,搅拌均匀得到混合溶液,(2)将步骤(1)得到的混合溶液在氮气氛围下300‑500℃焙烧1‑4 h后停止加热,在氮气氛围中冷却至室温后,得到磁性活性炭。本发明的磁性活性炭材料中的磁性介质为Ni0.5Zn0.5Fe2O4纳米材料,其磁性更强,分散性好,吸附性能更持久稳定,Ni、Zn、Fe元素的存在既增强了磁性活性炭脱汞性能又更易于磁性分离回收再利用。

本发明提供高响应恢复能力强的二硫化钼复合氧化锌气敏材料及制备工艺和应用,涉及光催化领域,二硫化钼的制备:将摩尔比为3:1的硫脲和钼酸钠溶解在25mL去离子水中,并充分搅拌;将所得溶液转移至50mL聚四氟乙烯衬里高压釜中,并在180℃下保持22h;随后,将获得的黑色沉淀物在氮气保护下以600℃退火2小时;在磁力搅拌的作用下,将1.14g醋酸锌和1.40g六亚甲基四胺溶解在40mL去离子水中,形成透明溶液;随后将MoS2添加到上述溶液中。搅拌均匀后,将溶液转移至100mL聚四氟乙烯衬里高压釜中,并在120℃下保持12h,用酒精和去离子水交替洗涤沉淀几次;最后,将产物在N2中以500℃和2℃·min‑1的加热速率退火2小时,从而获得MoS2/ZnO复合材料。

 926
926
 0
0
本发明公开了一种具有高效光催化活性的复合光催化材料及其制备方法,其中包括改性碳化氮、第一催化料、第二催化料、碳纤维和磷酸钠等组分,改性碳化氮是利用前驱体自组装共聚改性的方法制备得到的,采用的原料为三聚氰胺、三聚硫氰酸;第一催化料为Ag/Ag3PO4/BiPO4复合材料,第二催化料为CdS微球@TiO2核壳结构,第一催化料、第二催化料均具有优异的光催化活性和可见光利用率,再将第一催化料、第二催化料与改性碳化氮复合;本发明通过将第一催化料、第二催化料、改性碳化氮复合制备光催化材料,有效提高了光催化材料的可见光利用率,且该光催化材料的反应活性和光催化反应效率优异,具有较高的实用性。

 1052
1052
 0
0
本发明涉及一种3D打印的力学仿生耳廓软骨组织工程支架及其制造方法。它是通过3D打印技术,根据患者的个体耳廓软骨结构模型,打印出个性化的耳廓软骨支架,该组织工程支架由CN2019101396 57.9中公开的可3D打印聚‑L‑丙交酯‑己内酯(PLCL)与聚己内酯(PCL)生物可降解复合材料(PLCL‑PCL)打印而成,本发明无边框、多孔且孔隙贯通的耳廓软骨组织工程支架生物相容性、可降解性和热稳定性良好,具有耳廓软骨精细、复杂的三维立体结构,并具有与天然人耳廓软骨组织相应解剖区域相似的力学性能特点,适配于天然耳廓软骨的力学性能,可应用于个性化组织工程耳廓软骨的构建。

 1064
1064
 0
0
本发明涉及一种可收集钻削粉尘的钻削分层缺陷抑制装置及其抑制方法,属于纤维复合材料加工领域。可收集钻削粉尘的钻削分层缺陷抑制装置包括紧固套、压弹簧组件、固定套及锥形套;通过压弹簧组件推动固定套使得锥形套压紧待加工工件,并在钻削处形成密封空间,将固定套上的抽气口接入气泵或鼓风机的抽气口,即可在钻削粉尘收集装置内部形成负压,经由过滤装置可完成粉尘的收集;通过在待加工工件下方引入高压气体喷嘴,并建立了支撑气压p与轴向力分布载荷qc的对应关系,可在较高的轴向力载荷水平下完成无分层钻削。

 1072
1072
 0
0
本发明公开了一种HDPE动态结晶自动控制方法,其方法包括如下步骤:首先选取清洁的HDPE塑料,由于HDPE是烯烃类塑料,不会吸水,但为了产品质量,可对HDPE塑料进行烘干以排出浮水,将HDPE塑料放入螺杆剪切机的内部,HDPE料被剪切为小块颗粒,接着HDPE颗粒在通过加热圈时被加热融化为熔融态HDPE母料;本发明通过控制冷却水的温度和冷却时间,具有可以通过控制结晶时间和结晶速率从而控制材料的晶体大小和形状,保证HDPE能够有效且快速地进行结晶,从而提升了HDPE的结晶效果,进而能够保证HDPE管道性能稳定可靠的优点,解决了目前HDPE结晶效果并不好,导致生产得到的HDPE管道耐压性能较差,缩短了HDPE管道的使用寿命,从而限制了HDPE复合材料应用范围的问题。

 1097
1097
 0
0
本发明涉及电缆技术领域,提出了一种耐压耐高温电缆及其制备方法,包括电缆包括耐高温隔热层、耐压绝缘层和缆芯;所述缆芯包括由多条线芯绞合而成的导线以及包覆在导线外部的聚酰亚胺绕包,所述聚酰亚胺绕包中包含有一定量的纳米颗粒;所述耐高温隔热层由硅橡胶复合材料构由甲基乙烯基硅橡胶95~110份、乙烯甲基丙烯酸共聚物15~25份、改性硅灰石90~120份、氮化硼6~10份、氧化镁10~5份、气相二氧化硅25~34份,交联剂0.3~0.9份,硫化剂1.5~2.4份,羟基硅油3~7份,助溶剂12~18份制备而成。通过在硅橡胶基体内加入改性剂2,4,6,‑三羟基苯甲酸、针状硅灰石和N,N`‑1,3‑苯撑双马来酰亚胺,提高了硅橡胶的抗拉伸和抗冲击性能,提高陶瓷环硅橡胶外壳的均匀致密性。

 698
698
 0
0
本发明涉及一种抗菌剂的制备方法,通过十八烷基苯磺酸钠、环戊烷、乙醇及去离子水得溶液A;再将乙酸铜、硝酸铈、硫化钾及溶液A混合得溶液B,经过清洗过滤干燥得到掺杂Ce2+的CuS前驱体;该前驱体在120‑180℃反应后经过滤干燥即得掺杂Ce2+的CuS量子点类型的抗菌剂。本申请制备的抗菌剂为有较大比表面的CuS抗菌剂,由于Ce2+掺杂在CuS量子点中,可以有效降低CuS量子点的宽带间隙,能使CuS量子点在可见光下产生大量的活性氧簇,提高它的抗菌活性,能够很好的改善就热塑性塑料复合材料的抗菌性。
中冶有色为您提供最新的江苏有色金属复合材料技术理论与应用信息,涵盖发明专利、权利要求、说明书、技术领域、背景技术、实用新型内容及具体实施方式等有色技术内容。打造最具专业性的有色金属技术理论与应用平台!
 2025年10月23日 ~ 25日
2025年10月23日 ~ 25日  2025年10月31日 ~ 11月02日
2025年10月31日 ~ 11月02日  2025年11月07日 ~ 09日
2025年11月07日 ~ 09日  2025年11月14日 ~ 16日
2025年11月14日 ~ 16日  2025年11月14日 ~ 16日
2025年11月14日 ~ 16日 
